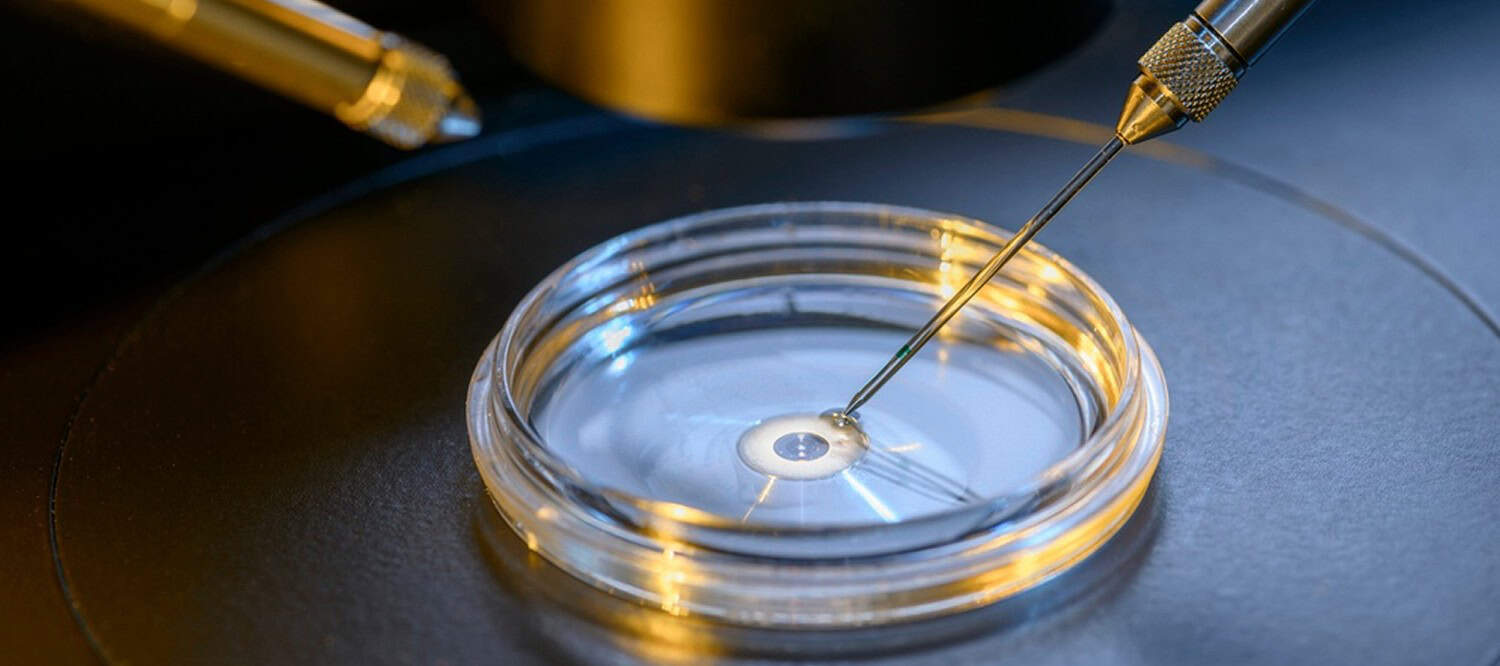

Le don d’ovocytes et de spermatozoïdes


La demande de don d’ovocytes
Les traitements d’assistance médicale à la procréation reposent sur la stimulation ovarienne.
Lorsque la réserve ovarienne est trop basse, le recours au traitement de stimulation ovarienne n’est pas concevable. En effet, dans ces cas, soit il n’y a pas de réponse à la stimulation soit cette dernière est beaucoup trop faible.
La réserve ovarienne peut être diminuée pour diverses raisons : cause génétique, conséquence d’un traitement par radiothérapie ou chimiothérapie, chirurgie ovarienne, contexte d’auto-immunité… mais on ne retrouve pas forcément la raison de cet appauvrissement de la réserve ovarienne.
Dans un contexte d’infertilité où la stimulation ovarienne n’est pas envisageable du fait de cette faible réserve ovarienne, une des alternatives efficaces pour obtenir une grossesse est le recours au don d’ovocytes. Le recours au don d’ovocytes peut également être envisagé pour éviter de transmettre une maladie génétique grave.
Le traitement consiste alors à préparer l’endomètre à recevoir l’embryon obtenu à partir d’un don d’ovocytes. Il s’agira de l’administration d’œstrogène puis de progestérone. Les ovaires ne sont pas stimulés.
Les caractéristiques physiques de la donneuse seront recueillies au préalable afin de correspondre dans la mesure du possible, à celles de la patiente recevant le don d’ovocytes.

La loi de bioéthique du 2 août 2021 introduit l’accès aux origines en ce qui concerne le don de gamètes. En effet, l’enfant issu de don aura la possibilité à sa majorité, s’il le souhaite d’accéder à certaines données concernant la donneuse. Il s’agit de données identifiantes (nom, prénom, date de naissance) et/ou de données non identifiantes (profession, caractéristiques physiques, pays de naissance, état de santé…). La donneuse doit nécessairement avoir consenti à transmettre ces informations la concernant avant de pouvoir donner ses ovocytes.
La constitution du dossier pour la demande de don d’ovocytes se fait sur six mois au cours desquels divers examens seront demandés (bilan sanguin, échographie pelvienne, autres examens d’imagerie…). Une consultation avec notre psychologue aura lieu ainsi qu’un rendez-vous avec un notaire pour établir le consentement pour l’AMP avec tiers donneur.
Dans le cadre d’une demande de couple, toutes les consultations devront être réalisées avec la présence des deux membres du couple. La prise en charge médicale est assurée à 100% par la sécurité sociale. À l’issue de la constitution du dossier, vous serez alors sur liste d’attente dans l’attente d’une donneuse vous correspondant.
Les délais d’attente peuvent être longs du fait de la pénurie de donneuses qui est nationale. En effet, les potentielles donneuses ne sont pas forcément informées de la possibilité de donner leurs ovocytes. De plus, il s’agit d’une démarche totalement altruiste. Nous sensibilisons donc au maximum le grand public au don d’ovocytes et nous vous encourageons à le faire afin de réduire les délais d’attente et offrir la possibilité de renouveler une tentative en cas d’absence de grossesse. Nous sommes joignables via notre adresse email pour renseigner les potentielles donneuses d’ovocytes intéressées (centre-de-reproduction@chu-nice.fr).
Pour plus d’informations, vous pouvez vous rendre sur le site de l’Agence de la biomédecine.
Donner ses ovocytes
Certaines personnes, dans un contexte d’infertilité, n’ont pas la possibilité de recourir à l’AMP intraconjugale et leur seule alternative pour réaliser leur rêve de devenir parent est le recours au don d’ovocytes.
Donner ses ovocytes est une démarche généreuse qui permet non pas de faire des enfants mais de faire des parents. Les donneuses sont ainsi souvent surnommées, par les personnes dans l’attente d’un don, leur « fée », ce qui en dit long sur l’importance que cela peut avoir dans leur vie.
Pour être donneuse, il faut être une femme âgée de 18 à 37 ans, munie d’une bonne réserve ovarienne.
Il s’agit d’une démarche altruiste et tout élément entraînant un sur-risque dans la procédure du don d’ovocytes ne permettra pas d’envisager le don pour des raisons de sécurité pour la donneuse.
Comme pour tout don, le principe de précaution s’applique. Ainsi, un recueil des antécédents personnels et familiaux de la donneuse sera réalisé. En effet, certains antécédents, notamment avec notion héréditaire, pourront contre-indiquer le don d’ovocytes.
Que la potentielle donneuse ait des enfants ou non n’est en aucun cas un critère pouvant contre-indiquer le don.
Il s’agit d’une démarche volontaire et gratuite. Néanmoins, tous les frais liés aux allers et venues dans notre centre, dans le cadre du don d’ovocytes (frais de transport +/- frais d’hébergement), sont remboursés dans un second temps par l’hôpital. La procédure est évidemment prise en charge à 100 % par la sécurité sociale dans le cadre d’une mission d’intérêt général.
La loi de bioéthique du 2 août 2021 introduit l’accès aux origines en ce qui concerne le don de gamètes. En effet, l’enfant issu de don aura la possibilité, s’il le souhaite, à sa majorité, d’accéder à certaines données concernant la donneuse. Il s’agit de données identifiantes (nom, prénom, date de naissance) et/ou de données non identifiantes (profession, caractéristiques physiques, pays de naissance, état de santé…). Si la donneuse refuse cette possibilité d’accéder aux origines, alors le don ne pourra pas être possible en accord avec la législation actuelle.
La procédure de don d’ovocytes s’organise à partir d’une première venue sur une matinée où la donneuse rencontre le gynécologue qui recueillera les informations nécessaires et qui réalisera une échographie pour avoir un premier aperçu de la réserve ovarienne. Au cours de cette première venue, une prise de sang sera également réalisée. Le bilan biologique comprendra les sérologies infectieuses, un bilan hormonal et un caryotype. Dans la même matinée, la potentielle donneuse rencontrera notre psychologue afin d’échanger sur les interrogations relatives au don d’ovocytes et ses implications. Enfin, la donneuse rencontrera les biologistes du service.
Pour réaliser un don d’ovocytes, le traitement consiste en l’administration quotidienne d’injections sous-cutanées à réaliser entre 18 heures et 20 heures pendant environ douze jours. Les injections peuvent être réalisées soit par la donneuse elle-même, soit par une infirmière à domicile. Au cours de cette douzaine de jours de stimulation ovarienne, trois à quatre contrôles échographiques et prises de sang auront lieu pour évaluer la réponse à la stimulation ovarienne. À l’issue de cette période, une ponction ovarienne sera programmée pour récupérer les ovocytes.
L’ensemble du traitement est expliqué et détaillé lors de la consultation, et une démonstration de la réalisation des injections est faite lors de la même venue. Vous pourrez également poser toutes les questions aux différents professionnels que vous rencontrerez. La réalisation du don ne va en aucun cas diminuer la réserve ovarienne de la donneuse.
Suite à cette première venue, une téléconsultation sera organisée. Elle permettra de discuter de l’ensemble des résultats des examens réalisés lors des premiers rendez-vous et de déterminer la période de la stimulation ovarienne. Elle sera décidée avec la donneuse, en fonction de ses disponibilités. Les ordonnances relatives au traitement lui seront envoyées par la suite, afin de lui éviter une venue supplémentaire.
Nous nous tenons à votre disposition, notamment via notre adresse email (centre-de-reproduction@chu-nice.fr), pour répondre à toutes interrogations avant un éventuel don d’ovocytes.
Pour plus d’informations, vous pouvez accéder à la brochure en lien ci-dessous.
La demande de don de spermatozoides
Dans certaines situations, les paramètres spermatiques ne permettent pas une prise en charge en AMP. Cela peut être le cas pour cause génétique, en cas de séquelles de certains traitements (chimiothérapie…), de conséquences infectieuses… Dans ces situations, la seule alternative efficace pour obtenir une grossesse est le recours au don de spermatozoïdes.
Depuis le passage de la loi de bioéthique du 2 août 2021, le don de sperme est également accessible aux couples de femmes et aux femmes non mariées.
Il s’agit alors d’avoir recours aux spermatozoïdes d’un donneur pour réaliser soit une insémination intra-utérine, soit une fécondation in vitro avec ICSI.
Les caractéristiques physiques du donneur sont recueillies au préalable afin de correspondre dans la mesure du possible à celles du patient, ou de la conjointe de la receveuse, ou à la receveuse elle-même.
La loi de bioéthique du 2 août 2021 introduit également l’accès aux origines en ce qui concerne le don de gamètes. En effet, l’enfant issu de don aura la possibilité à sa majorité, s’il le souhaite, d’accéder à certaines données concernant le donneur. Il s’agit de données identifiantes (nom, prénom, date de naissance) et/ou de données non identifiantes (profession, caractéristiques physiques, pays de naissance, état de santé…). Le donneur doit nécessairement avoir consenti à transmettre ces informations le concernant avant de pouvoir donner ses spermatozoïdes.

La constitution du dossier pour la demande de don de spermatozoïdes se fait sur six mois au cours desquels divers examens seront demandés (bilan sanguin, échographie pelvienne, autres examens d’imagerie…). Une consultation avec notre psychologue sera proposée ainsi qu’un rendez-vous avec un notaire pour établir le consentement pour l’AMP avec tiers donneur. Dans le cadre d’une demande de couple, toutes les consultations devront être réalisées avec la présence des deux membres du couple. La prise en charge médicale est assurée à 100% par la sécurité sociale. À l’issue de la constitution du dossier, vous serez alors sur liste d’attente, dans l’attente d’un donneur vous correspondant.
Nous sensibilisons le grand public au don de spermatozoïdes et nous vous encourageons à le faire également afin de maintenir des délais d’attente convenables.
Nous sommes joignables via notre adresse mail pour renseigner les potentiels donneurs de spermatozoïdes intéressés (centre-de-reproduction@chu-nice.fr).
Pour plus d’informations, vous pouvez vous rendre sur le site de l’Agence de la biomédecine.
Donner ses spermatozoïdes
Voici quelques précisions concernant l’organisation du don de spermatozoïdes dans notre CECOS.
Pour réaliser un don, vous devez :
- avoir plus de 18 et moins de 45 ans
- être en bonne santé.
- être en accord avec le principe d’accès aux origines : la Loi de Bioéthique du 2 août 2021 permet désormais aux enfants majeurs issus de don d’avoir accès à l’identité ainsi qu’aux données non identifiantes de leur donneur.
Dans un premier temps, une téléconsultation avec l’un de nos biologistes vous sera proposée. Lors de cette visioconférence, le biologiste réalisera une enquête génétique pour vérifier si vous pouvez être donneur. En effet, selon vos antécédents médicaux et ceux de votre famille, il arrive parfois que nous ne puissions pas accepter votre candidature en tant que donneur. Il est donc indispensable de bien préparer cet entretien en se renseignant au préalable sur les antécédents médicaux des membres de votre famille (parents, frère(s) et sœur(s), oncle(s) et tante(s), cousin(e)s, grands-parents).
Si votre candidature est acceptée, 4 rendez-vous vous seront proposés pour les prélèvements de sperme (plages horaires : 8h-11h, du lundi au vendredi, et hors jours fériés). Pour chaque prélèvement, un délai d’abstinence sexuelle de 2 à 7 jours est souhaitable. Tous les rendez-vous peuvent être étalés sur une période allant d’une semaine à 6 mois maximum, nous ferons au mieux pour nous adapter à vos disponibilités.

De plus, une consultation avec notre psychologue vous sera systématiquement proposée. Cette consultation a pour objectif de vous accompagner dans votre démarche. Elle pourra être pratiquée en présentiel ou à distance en téléconsultation.
Le jour de votre 1er prélèvement de sperme, une prise de sang ainsi qu’un prélèvement d’urine vous seront également demandés. Au terme de vos rendez-vous, vous devrez réaliser une 2ème prise de sang. L’ensemble de ces prélèvements est réalisé dans notre service. Si tous vos résultats sont satisfaisants, les spermatozoïdes congelés pourront alors être utilisés.
Informations pratiques :
Il sera nécessaire de venir au moins 4 fois dans notre laboratoire.
Lors de votre venue, n’oubliez pas d’amener votre carte d’identité, carte Vitale, ainsi que mutuelle de l’année en cours.Sachez que nous pouvons vous défrayer pour les frais occasionnés par le don : frais de déplacement, hébergement, repas. Pour cela, merci de nous fournir les justificatifs nécessaires (photocopie de carte grise, tickets de péage originaux, billets de train, carte vitale, RIB). Le remboursement sera fait a posteriori, par la direction de l’hôpital (comptez 2 à 3 mois de délai).
N’hésitez pas à nous contacter pour tout renseignement complémentaire ou pour fixer le premier rendez-vous.
